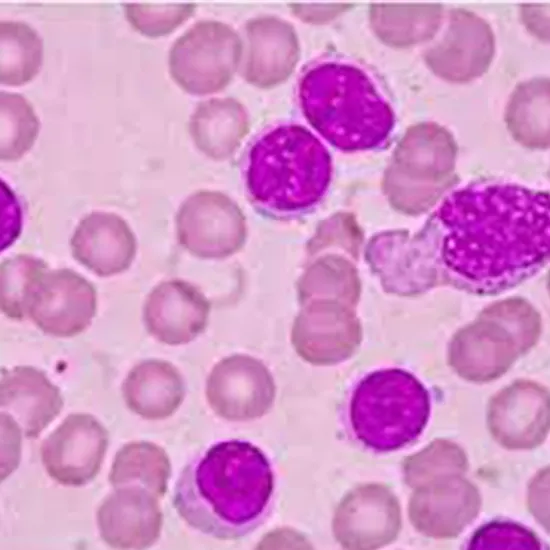

Book Chronic Lymphocytic Leukaemia (CLL) Prognostic Panel Appointment Online Near me at the best price in Delhi/NCR from Ganesh Diagnostic. NABL & NABH Accredited Diagnostic centre and Pathology lab in Delhi offering a wide range of Radiology & Pathology tests. Get Free Ambulance & Free Home Sample collection. 24X7 Hour Open. Call Now at 011-47-444-444 to Book your Chronic Lymphocytic Leukaemia (CLL) Prognostic Panel
Chronic lymphocytic leukaemia is a kind of blood and bone marrow cancer. This is a long-term condition and get advanced slowly unlike other leukaemia’s. this disease affects the white blood cells called lymphocytes that are responsible to protect our body from infections. This disease is most commonly found in older adults.
There is no certain known reason behind Chronic Lymphocytic Leukaemia. without any known reason mutations in DNA occurs and these DNA cells have already been instructed to make the inefficient white blood cells.
Chronic Lymphocytic Leukaemia (CLL) Prognostic Panel test uses the next generation sequencing method to make an assessment of 4 genes whose mutation could have been the cause of the disease.
If you are having following symptoms
Then Cost of Chronic Lymphocytic Leukaemia (CLL) Prognostic Panel test can be from INR 20,000 to INR 25,000.
Ganesh Diagnostic is one of the best service providers in pathology industry. We have latest machines and highly skilled technician that ensure that you have a highly accurate report and a very comfortable experience in the process.
| Test Type | Chronic Lymphocytic Leukaemia (CLL) Prognostic Panel |
| Includes | Chronic Lymphocytic Leukaemia (CLL) Prognostic Panel Test (Oncology) |
| Preparation | |
| Reporting | Within 24 hours* |
| Test Price |
₹ 23400
|

Early check ups are always better than delayed ones. Safety, precaution & care is depicted from the several health checkups. Here, we present simple & comprehensive health packages for any kind of testing to ensure the early prescribed treatment to safeguard your health.